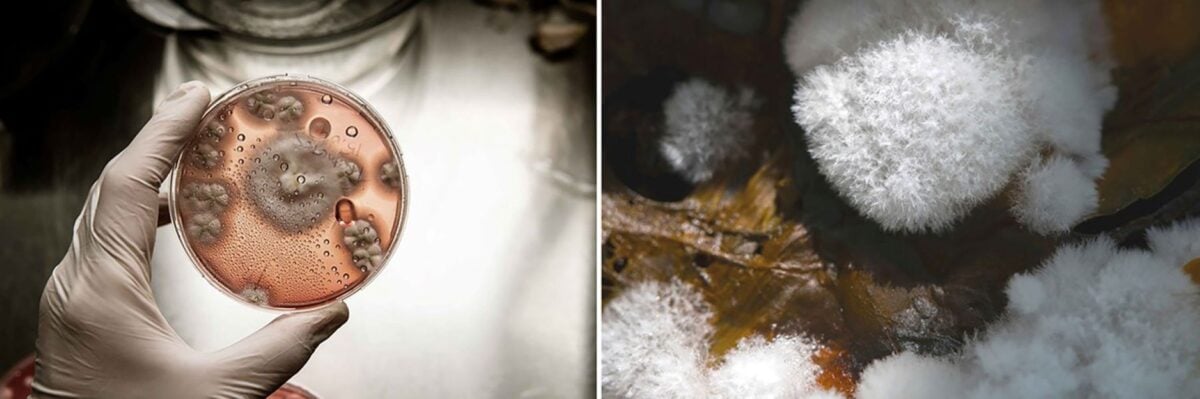
I biomateriali, Nuovo Rinascimento del design

I biomateriali, Nuovo Rinascimento del design
Il futuro dell’arredo non risiede più solo nella forma, ma nella biologia stessa della materia. La casa, infatti, sta diventando un ecosistema capace di curare l’ambiente tanto quanto il nostro benessere estetico.

Oggi la sostenibilità è sempre di più il cuore pulsante delle agende globali e delle politiche industriali più lungimiranti. Nel design, questa urgenza si traduce in una metamorfosi radicale: la materia non si estrae più, si coltiva o si recupera a tavola. Siamo di fronte a una rivoluzione sensoriale dove l’economia circolare smette i panni dimessi del “riciclato” per indossare quelli di un lusso consapevole, vibrante e iper-tecnologico. I veri protagonisti sono i biomateriali, alchimie contemporanee capaci di trasmutare lo scarto in poesia funzionale attraverso una simbiosi perfetta tra biologia e ingegneria. Basta guardare il lavoro di Krill Design, brand visionario che nobilita i residui dell’industria alimentare — dai fondi di caffè alle bucce d’arancia — in biopolimeri brevettati pronti a farsi oggetto attraverso la stampa 3D. O la Circular Sofa Platform un progetto avveniristico che coinvolge Politecnico di Milano, Università di Bologna, Politecnico di Torino e Università di Firenze e un team di ricercatori e imprese artigiane e distretti produttivi italiani: l’iniziativa, inserita nell’ambito di MICS – Made in Italy Circolare e Sostenibile e finanziata dal MUR con fondi PNRR, scardina l’anatomia degli imbottiti per renderli, finalmente, del tutto disassemblabili e biodegradabili. In un mondo che impone una riscrittura radicale dei cicli produttivi, quello che appare è una nuova estetica della responsabilità: dalla forza strutturale dei funghi alla bioluminescenza batterica, ecco alcuni progetti di spicco che stanno riscrivendo il codice genetico dell’abitare contemporaneo.
- Alternativa alla pelle
- L’alchimia del cuoio in provetta
- Reishi: il design che respira
- Metamorfosi terrena della plastica
- Nuove visioni in cemento
- Caldo come il sughero
- Il biocomposito che imita il corallo
- Noai, la pietra rigenerata
- Biomateriali che fanno luce
- La lampada che germoglia
- I batteri buoni che illuminano l’ambiente
- I biomateriali, Nuovo Rinascimento del design: foto e immagini
Alternativa alla pelle

L’alchimia del cuoio in provetta

Qorium è il capolavoro della biotecnologia applicata all’alto artigianato. Immaginate la texture vellutata e la resistenza meccanica di un cuoio pieno fiore, ottenuto però senza l’impatto etico e ambientale degli allevamenti intensivi. Non si tratta di un’imitazione sintetica, ma di un vero tessuto dermico coltivato in laboratorio partendo da colture cellulari: un processo di bio-fabbricazione che elimina sprechi, imperfezioni ed emissioni di metano. Per il mondo dell’interior, Qorium rappresenta il “sacro graal”: la possibilità di rivestire divani e poltrone con un materiale che possiede il DNA della pelle, ma la purezza di un processo controllato e circolare. Un lusso che interpreta l’esclusività nella perfezione molecolare: ogni centimetro quadrato è progettato per durare, emozionare e, soprattutto, rispettare l’ambiente.
Reishi: il design che respira

Se il lusso ha sempre avuto il tocco della pelle, Ligne Roset ne riscrive il canone estetico ed etico attraverso il Reishi. Non chiamatelo sostituto, perché questo materiale derivato dal micelio — l’apparato radicale dei funghi — possiede una nobiltà tattile e visiva che sfida i pellami più pregiati. Frutto di una bio-fabbricazione d’avanguardia, il Reishi cresce in strutture cellulari dense e resilienti, offrendo una morbidezza organica che sembra trattenere il calore della terra. Scegliendo questa “pelle senza animale” per i suoi pezzi iconici, il brand francese non si limita a vestire il comfort, ma celebra una nuova era dove l’arredo è un organismo vivo. È la prova tangibile che l’alta ebanisteria e la micologia possono dialogare, creando oggetti che non solo arredano lo spazio, ma lo nobilitano con una sostenibilità finalmente sensuale e senza compromessi.
Metamorfosi terrena della plastica

Con la collezione Tierra, Guzzini dimostra che la plastica, se guidata dal design d’autore, può ambire a una seconda vita intrisa di fascino artigianale. Non siamo di fronte a un semplice contenitore, ma a un manifesto di circular design dove il polimero riciclato post-consumo — derivato dal recupero delle bottiglie in PET — ritrova la dignità di un materiale nobile. La mano di Pio e Tito Toso ha plasmato superfici vibranti, caratterizzate da una matericità quasi ancestrale che evoca le irregolarità della ceramica tornita a mano. È il paradosso perfetto: un materiale ultra-industriale che si riscopre caldo, tattile e profondamente legato alla terra. Ogni pezzo della linea Tierra non si limita a servire in tavola, ma racconta una storia di rigenerazione urbana e industriale, provando che il riciclo è una piccola rivoluzione quotidiana e accessibile. E che la sostenibilità di massa può (e deve) essere bellissima.
Nuove visioni in cemento

Caldo come il sughero

Con Corkcrete, Opinion Ciatti riscrive le regole dei materiali minerali attraverso una sintesi audace tra solidità e leggerezza. La scommessa è audace: iniettare un’anima gentile e profondamente umana in una materia minerale. E il risultato è una resina cementizia, nobilitata da granuli di sughero, che trasforma la brutalità del cemento in una materia vibrante e termicamente intelligente. Accarezzare il piano di un tavolino Ptolemeo Art diventa così un’esperienza sorprendente: la porosità del sughero smussa la rigidità della pietra, regalando una superficie che non è solo bella da guardare, ma piacevole da vivere. Non è solo questione di sostenibilità, ma di intelligenza materica: il Corkcrete assorbe i suoni, trattiene il calore e nobilita lo scarto, elevando un’alleanza apparentemente impossibile a nuovo standard del lusso architettonico.
Il biocomposito che imita il corallo

Ancora cemento, con il bio-composito di Prometheus Materials che rappresenta forse la sfida più radicale alla crisi climatica. Ispirandosi al modo in cui la natura costruisce le barriere coralline, questa start-up utilizza microalghe marine per sintetizzare un biocemento che, invece di emettere CO2, la sequestra. Risultato? Un materiale strutturale dalle prestazioni meccaniche eccellenti, che “imita” il cemento, ma con un’impronta carbonica negativa. Fare entrare questo materiale vivente in uffici, abitazioni, hotel significa progettare edifici che respirano e utilizzano le pareti come strumenti attivi per rigenerare l’ambiente.
Noai, la pietra rigenerata

La ricerca di Living Divani celebra la circolarità del design sostenibile con il tavolino Etoile, interpretato da Marco Carini nella versione in Noai®. Qui la sfida è nobilitare i residui di processi industriali con “un impasto di terra cruda, fibra di canapa, ossidi minerali e quarzi pregiati, leganti vegetali, un po’ di sale e un po’ di acqua” come racconta il designer, trasformandoli in una superficie rigenerata dalla profondità cromatica sorprendente. Noai® non è un semplice rivestimento, ma una materia nuova brevettata che simula la pietra senza doverla estrarre, conferendo al piano una densità materica quasi lapidea. Ma soprattutto, è un materiale naturale che vanta anche proprietà fotocatalitiche, contribuendo a migliorare la qualità dell’aria negli spazi in cui viene inserito, che siano indoor oppure outdoor. Ed è totalmente compostabile.
Biomateriali che fanno luce
La lampada che germoglia

Se il design è sempre stato l’arte di plasmare la materia, Danielle Trofe sposta il confine più in là: con Mushlume, la luce non si fabbrica, si accudisce mentre germoglia. Queste lampade “naturali” infatti non vengono assemblate, ma letteralmente coltivate combinando scarti agricoli e micelio. Il risultato è un paralume dalla texture vellutata e lunare, una geometria organica che sfida la freddezza della plastica. Ogni pezzo è unico, nato da un processo di crescita naturale che si conclude con la completa biodegradabilità. È il design che torna alla terra, dimostrando che l’estetica del futuro ha la consistenza soffice di un organismo vivente.
I batteri buoni che illuminano l’ambiente

Osservando questa lampada si apre un immaginario da fantascienza biologica, in cui i batteri invadono lo spazio. Solo che qui non fanno paura, ma generano possibilità. Gathering Lamp di Normal Phenomena of Life (NPoL), infatti, non funziona con i classici circuiti elettronici, ma è attivata – incredibile – da batteri bioluminescenti. La luce non è più un flusso statico, ma un fenomeno biologico che pulsa di vita propria. È un’opera che ridefinisce il nostro rapporto con l’energia: la Gathering Lamp non si limita a illuminare, ma richiede cura, ricordandoci che il futuro dell’abitare è una convivenza simbiotica con il mondo naturale.
I biomateriali, Nuovo Rinascimento del design: foto e immagini